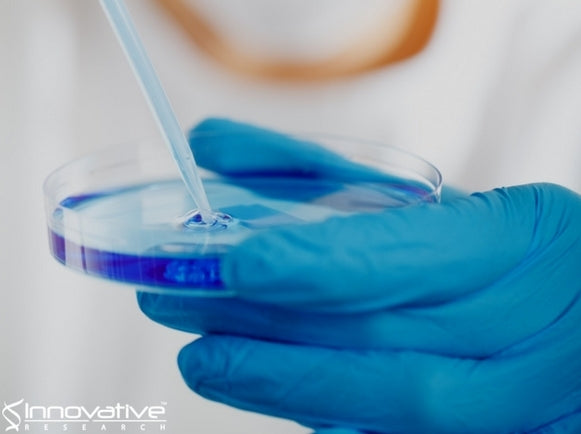

What, exactly, are iPS cells? And why are they so interesting?
In a lab setting, induced pluripotent stem cells (iPS cells, for short) can become various types of cells and tissues, making them a cornerstone of regenerative medicine with seemingly endless applications for repairing damage due to trauma or disease.
Now, as ScienceDaily reports, a study in mice suggests that iPS cells could be used to train the immune system to attack (or possibly even prevent) tumors, which could pave the way for the possibility of a "cancer vaccine" that is individually tailored using a person's own iPS cells to protect against various forms of cancer.
How iPS cells work against cancer
In general, iPS cells are similar (on their surface) to tumor cells. Both resemble developmentally immature progenitor cells — which means that both iPS and tumor cells are free from the growth restrictions that are seen in mature tissue cells.
Because of this, injecting iPS cells that genetically match the individual (but that are unable to replicate) can provide safe exposure to a range of cancer-specific targets, according to new research recently published by Stanford Medicine.
As part of a potential vaccine, iPS cells have strong immunogenic properties that are able to induce a systemic cancer-specific immune response.
Creating iPS cells
Researchers are able to create iPS cells from an easily-accessible source, like skin cells or blood cells. The collected cells then undergo genetic treatment which essentially turns back the clock, developmentally speaking, to a pluripotent stage — meaning that the cells are able to develop from that stage into nearly any tissue of the body.
How it worked in mouse testing
In comparing gene expression between iPS and cancer cells in both mice and humans, researchers identified remarkable similarities that suggested these types of cells both contain the same surface proteins (epitopes) that could serve as immune targets.
This was tested in four groups of mice — the first group was injected with a control, the second received iPS cells that were a genetic match and irradiated, the third received a generic immune-stimulating agent, and the fourth and final group received both irradiated iPS cells and the immune-stimulating agent. A mouse breast cancer cell line was transplanted into all mice involved in the study so that potential tumor growth could be observed.
A week later, all of the mice had developed breast cancer tumors at the injection site. In the control groups, these tumors proceeded to grow robustly. In 7 of the 10 mice from the fourth group (receiving both the iPS cells and the immune-stimulating agent), the tumors shrank in size, and two of these mice were able to reject the cancer cells completely and live for more than one year following the tumor transplant. Similar results occurred when tested with mouse melanoma and mesothelioma.
What's next
The scientists involve believe this approach is especially powerful since it allows for exposure to different types of cancer-specific epitopes at the same time, putting the immune system on alert and allowing it to target cancers as they begin to develop.
Next, the team would like to study if this approach would work with samples of human cancers and immune cells in a laboratory setting.
The future looks bright, if this research continues to perform as expected, for creating a personalized vaccine using an individual's own iPS cells to prevent cancer development for months or years. Additionally, this could potentially be used as part of cancer therapy, alongside surgery, chemotherapy, radiation, or a combination thereof.
While much research remains to be done, the concept is certainly exciting — and we may be just around the proverbial corner from the development of better cancer treatment and prevention.
Further Reading & References:
Nigel G. Kooreman, Youngkyun Kim, Patricia E. de Almeida, Vittavat Termglinchan, Sebastian Diecke, Ning-Yi Shao, Tzu-Tang Wei, Hyoju Yi, Devaveena Dey, Raman Nelakanti, Thomas P. Brouwer, David T. Paik, Idit Sagiv-Barfi, Arnold Han, Paul H.A. Quax, Jaap F. Hamming, Ronald Levy, Mark M. Davis, Joseph C. Wu. Autologous iPSC-Based Vaccines Elicit Anti-tumor Responses In Vivo. Cell Stem Cell, 2018; DOI: 10.1016/j.stem.2018.01.016
Stanford Medicine. "Induced pluripotent stem cells could serve as cancer vaccine." ScienceDaily. ScienceDaily, 15 February 2018. www.sciencedaily.com/releases/2018/02/180215125026.htm.
Innovative Research was established in 1998 after the realization that dependable, high-quality, and affordable research materials were hard to come by. Starting with core products like human plasma and serum, Innovative Research has grown to be a trusted supplier of all lab reagents, including human biologicals and ELISA kits. Today, we manufacture and supply over 3,000 high-quality human and animal biologicals including plasma, serum, tissues, and proteins.